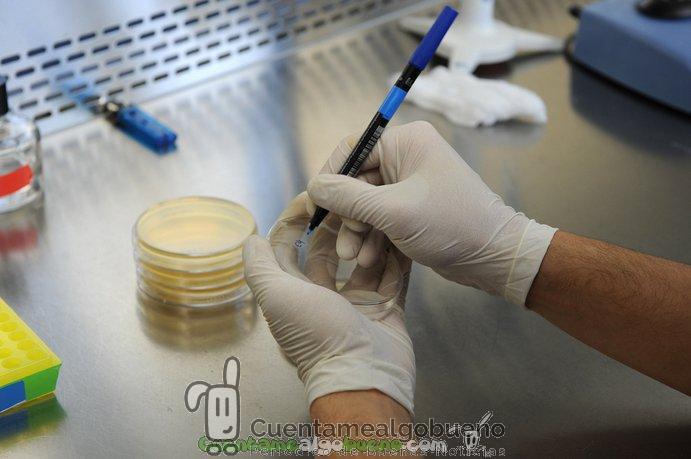

- El Consejo Europeo de Investigación ha publicado los resultados de la primera convocatoria Starting Grant.
- España ha obtenido un total de 20 ayudas y cada proyecto elegido contará con un máximo de 2 millones de euros.
- La convocatoria está enmarcada dentro del programa de investigación e innovación Horizonte 2020.
España ha obtenido un total de 20 ayudas de la primera convocatoria Starting Grant dentro del programa de investigación e innovación Horizonte 2020, que otorga el Consejo Europeo de Investigación (ERC, en sus siglas en inglés).

Las Starting Grant están dirigidas a investigadores excelentes que tengan una experiencia posdoctoral de entre 2 y 7 años. Foto: CITA.
«Estos resultados mejoran los obtenidos en 2013, especialmente en lo concerniente a la tasa de éxito, que pasa del 4,1% en 2013 al 7,8% en 2014, y en el número de proyectos financiados, ya que el año pasado España consiguió 14», asegura un comunicado del Ministerio de Economía y Competitividad.
En esta primera convocatoria de Horizonte 2020 se han seleccionado 328 proyectos por un total de 485 millones de euros. Los investigadores seleccionados pertenecen a 38 países diferentes, europeos y no europeos, que realizarán su investigación en 180 instituciones por toda Europa.
Las Starting Grant están dirigidas a investigadores excelentes que tengan una experiencia posdoctoral de entre 2 y 7 años. Estas ayudas van dirigidas a investigaciones que se desarrollen en la frontera del conocimiento en alguna de estas tres áreas: Ciencias de la Vida, Ciencias Físicas e Ingeniería y Ciencias Sociales y Humanidades.
Los investigadores que las obtienen podrán crear sus propios grupos de investigación, para lo que contarán con un máximo de 2 millones de euros por proyecto.
España ha obtenido 20 ayudas distribuidas de la siguiente manera:
- 11 proyectos del área Ciencias de la Vida.
- 6 en Ciencias Físicas e Ingeniería.
- 3 en Ciencias Sociales y Humanidades.
Además, ha aumentado el número de mujeres que ha obtenido una ayuda Starting Grant, cinco este año frente a las tres científicas de 2013.
Fuente: sinc. Más información en http://erc.europa.eu/.